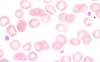

Kurzbeschreibung:
Durch antithrombozytäre Autoantikörper hervorgerufene Thrombozytopenie. Man unterscheidet eine akute und eine chronische Form sowie eine idiopathische (ohne erkannbare Ursache) und eine sekundäre Form (bei bekannter Begleitkrankheit).
Klinisches Bild:
Bei Kindern kommt es im Anschluss an einen unspezifischen viralen Infekt zu einer plötzlichen Blutungsneigung, vor allem der Haut. Schwere Blutungen sind selten. Auf eine Therapie kann oft verzichtet werden. Bei über 90% der Kinder verschwindet die Thrombozytopenie innert Wochen spontan.
Bei Erwachsenen kann entweder ein plötzliches Auftreten oder ein schleichend progredienter Verlauf beobachtet werden. Es findet sich ein Häufigkeitsgipfel bei jüngeren Frauen und bei älteren Menschen. Das Verhältnis zwischen Frauen und Männer beträgt 3 : 1. Selbst wenn die Thrombozyten unter 5 x 109/L fallen, sind schwerwiegende Blutungen selten. Meist beschränkt sich die Symptomatik auf generalisierte Petechien (Punktblutungen) und Hämatome ohne adäquate Traumata, sogenanntes "easy bruising" (englisch bruise = blauer Fleck). Die sekundäre ITP kommt zum Beispiel bei lymphoproliferativen Syndromen oder Kollagenosen wie dem systemischen Lupus erythematodes vor.
Therapie:
Die Therapie besteht primär aus oralen oder intravenösen Kortikosteroiden. Bei Blutungsnotfällen können intravenöse Immunglobuline oft einen raschen Anstieg der Thrombozyten bewirken. Deren Ansprechen hält aber nur einige Wochen an. Bei Rezidiven oder therapieresistenten Fällen kommt die Splenektomie oder eine Immuntherapie mit dem anti-CD20-Antikörper Rituximab (Mabthera) in Frage. Chronische Verläufe können mit Thrombopoietin-Rezeptor-Agonisten wie Eltrombopag (Revolade) oder Romiplostim (Nplate) behandelt werden.
Hämatologie:
Im Blutbild fällt neben der oft sehr schweren Thrombozytopenie eine Thrombozyten-Anisozytose auf. Die Thrombozyten sind normalgross bis vergrössert. Gelegentlich finden sich Riesenplättchen. Die Thrombozytengranulation ist unauffällig.
Knochenmark:

Im Knochenmark kann die Megakaryopoiese stark gesteigert sein. Zum Teil ist die Megakaryopoiese im Verhältnis zum Schweregrad der Thrombozytopenie aber auch ungenügend vermehrt. Neben zahlreichen jungen Megakaryozyten mit basophilen Zytoplasma und monolobuliertem Kern ist die Mehrheit gross und reif mit polylobulierten Kernen.